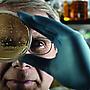

作者查詢 / Tsukaima
作者 Tsukaima 在 PTT 全部看板的留言(推文), 共537則
限定看板:全部
看板排序:
全部Stock117Nuggets66IVERSON47pharmacist45StupidClown18Salary17Japandrama16Gossiping14Mancare12CNU11Lifeismoney10Hate9NHSH13th3059Beauty8Keelung8sex8STREET_BALL7Taoyuan7Boy-Girl5SHORTY5tax5YuiAragaki5cksh84th3214Navy4Pharmacy4MenTalk3Reptile3THUIM-1st3BT95A3-4-5-62FJU-ACCR942HSNU_10982medstudent2N_E_Coastal2NTUmed912WomenTalk2basketball1BeautySalon1Chan_Mou1cksh79th011cksh81st3211cksh85th3071CSMU-MED951customers1DivingSport1e-coupon1feminine_sex1Food1gift1Grizzlies1hairdo1HLHS_10thU1HSNU_10081HSNU_8201joke1Journalism961KenShin1KERORO1KG95-3041KLSH1kodomo1KSU1KUAS1maruko1marvel1Militarylife1Mix_Match1NBA1NCCU04_TUR1nobunyaga1NTUE-PD011ntufiction1Oni_soul1Oracles1Perfume1PolBadminton1Rockets1Scorpio1scutran_city1single1specialman1SYSOP1t-management1TA_AN1THU-CHEM941THUIM-5th1TigerBlue1UglyClub1Violation1<< 收起看板(88)
117F推: 謝謝大樹哥~XD06/25 07:33
6F推: N95微酸...這05/24 23:14
193F推: 醒醒吧!是擇日啊!敷衍你的!!!05/06 18:37
1F推: 中山區也停電了...05/03 12:35
117F推: 八八!!!!03/11 20:00
36F推: 優~02/19 19:06
2F推: 感謝分享新知02/01 23:37
10F推: 多爬文+1,別當掃雷兵。02/01 23:39
390F推: 感到溫馨,但你沒救了..01/06 23:13
110F推: a圖王!!!圖片暖暖的01/07 00:00